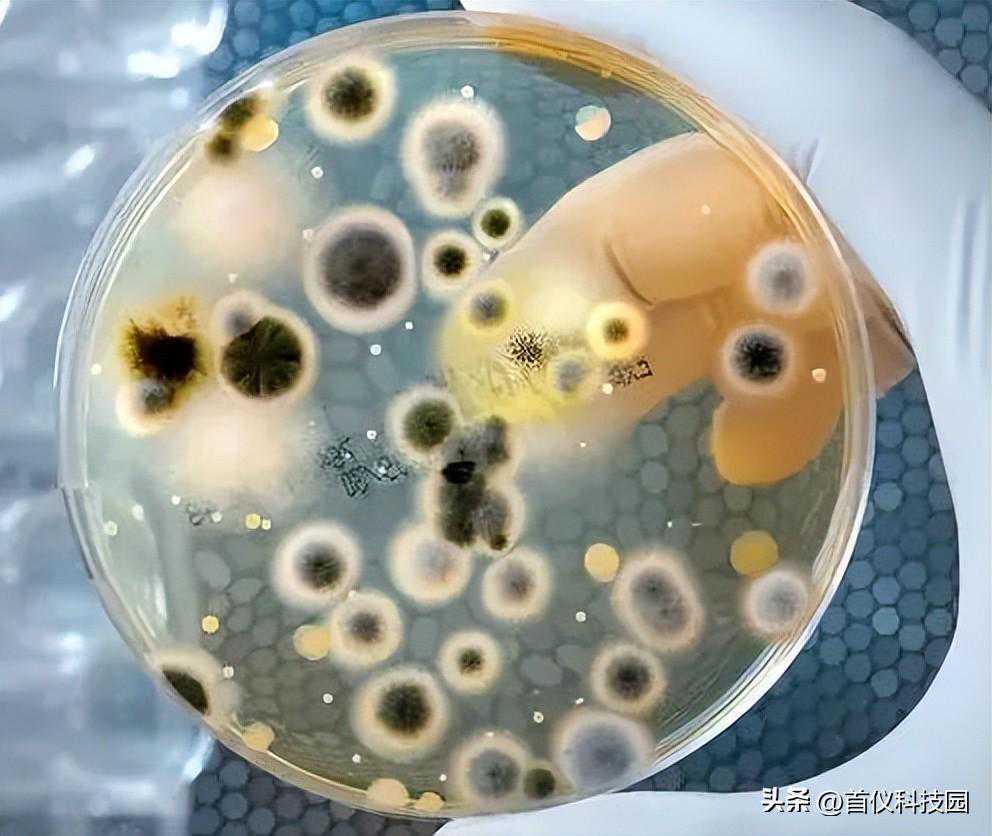

软膏剂(Ointments)是系指药物与适宜基质均匀混合制成的具有一定稠度的半固体外用制剂。其中含有的药物可以溶解或分散于基质中。用乳剂型基质制成的软膏剂称乳膏剂。

乳膏剂中的水分一般以结合水和非结合水的形式存在,只有非结合水能被微生物生长、繁殖和孢子萌发所利用。水分活度反映乳膏剂中微生物新陈代谢可利用水(非结合水)的量度,通常用水分的饱和蒸气压和纯水饱和蒸气压(相同温度下)的比值表示,数值为0~1。

水分活度是食品安全控制和质量控制的重要指标。《美国食品生产过程良好操作规范》要求,将水分活度作为反映食品安全性的重要指标;《危害分析和关键控制点(HACCP)体系及其应用指南》GB/T19538—2004中规定,可通过限制水分活度来控制微生物病原体的生长。在药品中水分活度的应用仅体现在《美国药典(41版)》中收载的《非无菌药物制剂水分活度测定的应用指导原则》中。

采用Aqualab型水分活度仪测定市售乳膏剂的水分活度,以0.25,0.50,0.76,0.92水分活度标准溶液对仪器进行多点校准。实验时,AquaLab循环读数,直到水分活度3次连续读数间的差值小于0.0005时,仪器达到平衡,并准确读数。每个样品重复测定3次,取平均值。

水分活度在乳膏剂中的应用
乳膏剂的水分活度与潜在微生物的生长、繁殖密切相关,了解其中的水分活度具有以下意义:1)可评估该剂型的潜在污染菌和不可接受微生物,建立该剂型微生物检测指标,降低微生物污染风险;2)通过风险评估减少乳膏剂微生物检查频次,提供合理的微生物控制策略;3)优化乳膏剂处方,降低水分活度,提高药品对潜在微生物的自身防腐能力;4)对乳膏剂包装的密闭系统提出更高的要求,阻止水分进入包装体系。
建立微生物检测指标,合理控制微生物污染
微生物的生长与水分活度密切相关,不同类型的微生物均有最低水分活度要求,当药品的水分活度低于此临界值时,该类型的微生物将无法生长。革兰阴性菌铜绿假单胞菌、大肠埃希菌、沙门菌属、洋葱伯克霍尔德菌的最低水分活度分别为0.97,0.95,0.95,0.95;革兰阳性菌金黄色葡萄球菌的最低水分活度为0.86;芽孢杆菌属蜡样芽孢杆菌和枯草芽孢杆菌的最低水分活度分别为0.95和0.80;真菌白色念珠菌和黑曲霉的最低水分活度分别为0.87和0.77;最耐高渗酵母菌和耐旱真菌的水分活度低于0.60时无法增殖。

目前共检测过市售的108批次乳膏剂,其中聚维酮碘乳膏的水分活度为0.5719,其余乳膏剂的平均水分活度在0.8353~0.9987之间。适合多数革兰阴性菌、革兰阳性菌、部分芽孢杆菌属、霉菌、酵母菌的生长,主要潜在污染菌为革兰阴性菌。
对于这个水分活度下的样品,后续应检测需氧菌总数、霉菌及酵母菌总数;而乳膏剂为外用制剂,故还需检测金黄色葡萄球菌和铜绿假单胞菌条件致病菌。从水分活度指标上看,聚维酮碘乳膏不适合任何微生物生长繁殖,但不表示不存在微生物。故水分活度是非无菌制剂微生物控制体系的有力补充,但不能完全代替微生物限度检查。
提供合理微生物控制策略的有力工具
对于水分活度较低的乳膏剂,由于其不支持孢子萌发或微生物生长,可通过风险评估来减少微生物限度检查的频次,实施跳批次检查,甚至可取消微生物常规检查。风险评估包括乳膏剂开发、生产、过程验证、常规检查(至少20批次)的微生物历史监测数据,以及证明原材料、制药用水、生产过程、制剂、包装体系的微生物控制策略是否具有有效性。

如聚维酮碘乳膏的水分活度为0.5719,该生产企业可对此产品进行风险评估,实施跳批次检查,建立符合产品特征的日常微生物控制策略,节约成本,提高效率。
优化处方,提高乳膏剂自身防腐能力
降低乳膏剂水分活度可有效阻止微生物的生长与繁殖。对于已上市乳膏剂水分活度为0.8353~0.9987或处于研发阶段的乳膏剂,可对其水分活度进行评估,并优化处方,以提高药品的自身防腐能力。如通过微调氯化钠、蔗糖、乙醇、丙二醇或甘油的处方量,将药品中的自由水转变为结合水,降低乳膏剂的水分活度,从而阻碍乳膏剂中潜在微生物的生长。

建立非无菌制剂中水分活度应用指导原则
美国药典通则-微生物学专家委员会提议修订美国药典USP1112“水分活度测定在非无菌制剂中的应用”。METERGroup,Inc.公司的应用科学家应邀对该提案进行修改和讨论。
目前,2020年版《中国药典》借鉴了国外药典的理念,并结合国情对乳膏剂微生物限度检查等内容作了较大修订,但仍未建立水分活度测定方法,也未收载水分活度在非无菌制剂中应用的相关指导原则。按照行业发展趋势,制定水分活度在非无菌制剂中应用指导原则,完善制药行业微生物污染的过程控制和源头控制已势在必行。
